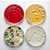
PLACA DE PETRI 90X15MM S/DIVISAO - PCT/10 - OLEN - Imagem 4

Aplicação: Ideais para procedimentos laboratoriais em microbiologia e análises clínicas.
Utilizadas para crescimento e identificação de microrganismos, documentação de colônias, rotinas de bacteriologia, entre outros.
Características:
- Fabricadas em poliestireno de alta transparência;
- Superfície plana;
- Tampa com marcas de ventilação que permitem a circulação de ar e impedem a condensação;
- 90 x 15 mm;
- Estéril por radiação ionizante.
- Apresentação: 10 unidades por pacote.
Código: K30-9015RI
Marca: OLEN
Produtos relacionados
-
 PLACA DE PETRI 90X15MM C/ 1 DIVISORIA RADIAÇAO IONIZANTE - CX/200 - OLENR$ 145,98ou R$ 143,06 via Pix
PLACA DE PETRI 90X15MM C/ 1 DIVISORIA RADIAÇAO IONIZANTE - CX/200 - OLENR$ 145,98ou R$ 143,06 via Pix
A Lab-Bran atua há mais de 20 anos entregando insumos com precisão, responsabilidade e documentação correta pra quem não pode errar no laboratório. Atendemos hospitais, clínicas médicas e veterinárias, universidades, laboratórios de análises, indústrias e agronegócio — com estoque técnico e emissão fiscal pronta pra cada tipo de cliente. Seja qual for sua área, se você precisa de insumos confiáveis, pode contar com a Lab-Bran.